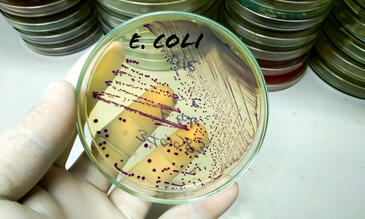

The Centre for Drugs and Diagnostics at the Liverpool School of Tropical Medicine comprises an experienced multi-disciplinary group of experts working together to develop new drugs and diagnostics. Using state-of-the art laboratories and equipment, the group regularly works with industry, academia and other NGOs to discover, develop and deliver novel therapies and diagnostics against a range of pathogens.